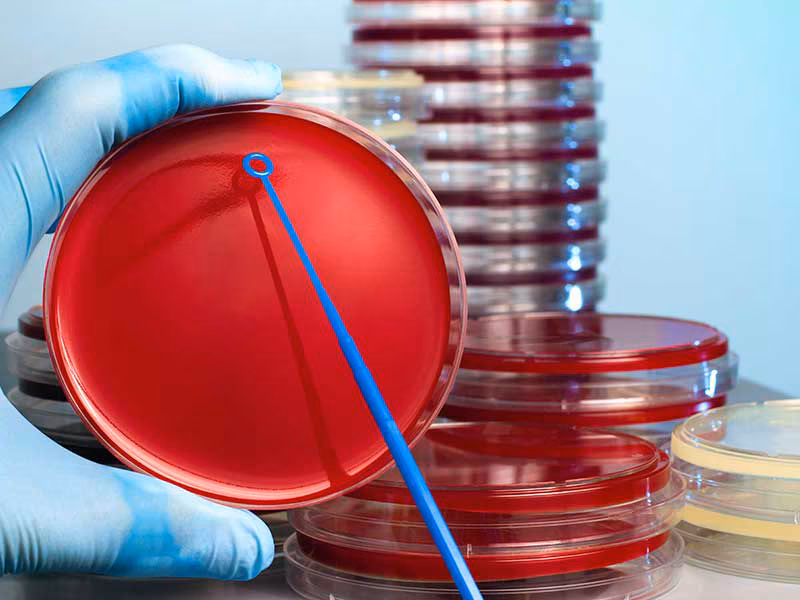

Our Product Categories
As Tanzania's leading medical supply partner, we provide world-class laboratory and medical equipment from trusted global manufacturers to healthcare facilities nationwide.
Comprehensive Medical & Laboratory Solutions
Browse our extensive range of medical and laboratory products. Each category features detailed product information and downloadable fliers for your reference.

Advanced clinical chemistry solutions encompassing reagents, systems, photometers, and ISE analyzers designed to meet the demands of modern laboratories.
View Details
Automated hematology (CBC) products designed for small to large laboratories, offering throughput ranges from 30 to 80 samples per hour.
View Details
Comprehensive microbiology solutions for pathogen identification and antimicrobial susceptibility testing.
View Details
Advanced microfluidic technology for precise fluorescence-based immunoassays with rapid results.
View Details
Critical care blood gas analyzers for rapid and accurate patient monitoring in emergency and intensive care settings.
View Details
Quick and reliable rapid diagnostic tests for immediate results in point-of-care testing environments.
View Details
Comprehensive coagulation testing solutions for accurate hemostasis diagnostics with advanced analyzers and quality reagents.
View Details
Diverse range of high-quality laboratory equipment designed to meet the needs of laboratories worldwide, from essential tools to specialized instruments.
View Details
Advanced autoimmune diagnostic solutions for detecting autoimmune diseases with precision and reliability.
View Details
Comprehensive range of general medical equipment for healthcare facilities, including monitoring devices and essential medical instruments.
View Details
Complete urinalysis solutions including automated analyzers and reagent strips for comprehensive urine testing.
View Details
Innovative tuberculosis detection solutions using LAMP technology for rapid and accurate TB diagnosis.
View Details
Essential laboratory consumables including reagents, test strips, and disposable items for daily laboratory operations.
View DetailsNeed Custom Solutions?
Can't find exactly what you're looking for? As Tanzania's premier medical supply partner, we can source specialized equipment and products to meet your specific requirements.
Contact Our Experts